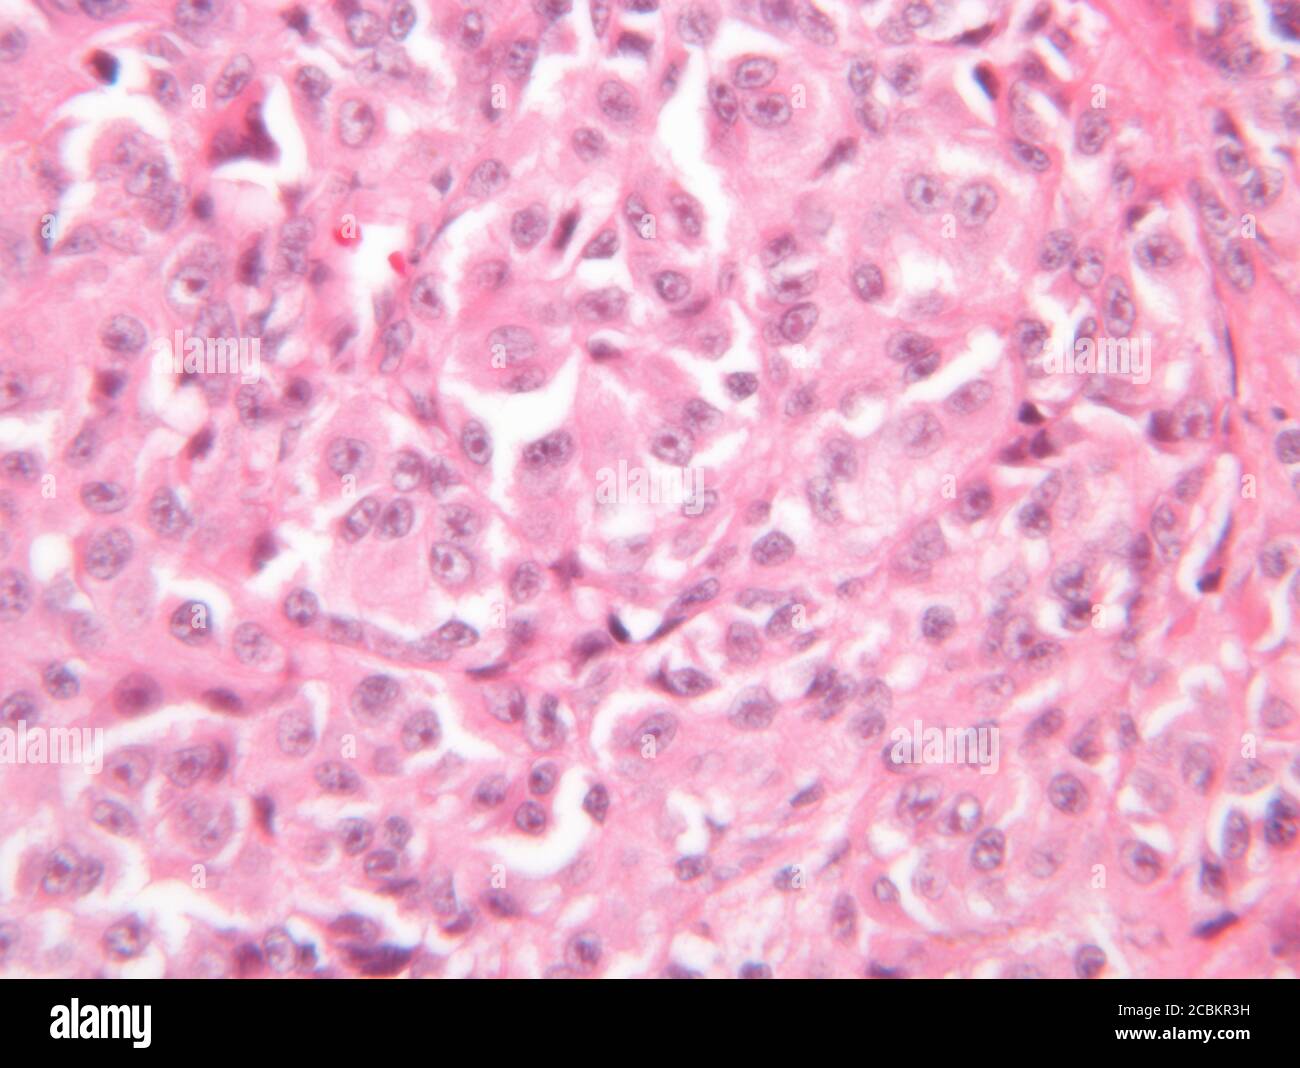
Vista al microscopio del melanoma maligno Foto Stock

Malignant melanoma Immagini Stock
(2,408)Filtri rapidi:
Malignant melanoma Immagini Stock
 Il melanoma maligno Foto Stockhttps://www.alamy.it/image-license-details/?v=1https://www.alamy.it/foto-immagine-il-melanoma-maligno-49289317.html
Il melanoma maligno Foto Stockhttps://www.alamy.it/image-license-details/?v=1https://www.alamy.it/foto-immagine-il-melanoma-maligno-49289317.htmlRMCT590N–Il melanoma maligno
 Una grande mole su un uomo con la schiena che presentano segni di melanoma, confermato più tardi. Foto Stockhttps://www.alamy.it/image-license-details/?v=1https://www.alamy.it/foto-immagine-una-grande-mole-su-un-uomo-con-la-schiena-che-presentano-segni-di-melanoma-confermato-piu-tardi-49090922.html
Una grande mole su un uomo con la schiena che presentano segni di melanoma, confermato più tardi. Foto Stockhttps://www.alamy.it/image-license-details/?v=1https://www.alamy.it/foto-immagine-una-grande-mole-su-un-uomo-con-la-schiena-che-presentano-segni-di-melanoma-confermato-piu-tardi-49090922.htmlRMCRT7Y6–Una grande mole su un uomo con la schiena che presentano segni di melanoma, confermato più tardi.
 Basale, cancro, carcinoma, dermatologia, maligno, melanoma cutaneo, sun, tumore, illustrazione, artwork, cancerosi, insalubri, anormale, mole, lesione, medicina, medico, Foto Stockhttps://www.alamy.it/image-license-details/?v=1https://www.alamy.it/foto-immagine-basale-cancro-carcinoma-dermatologia-maligno-melanoma-cutaneo-sun-tumore-illustrazione-artwork-cancerosi-insalubri-anormale-mole-lesione-medicina-medico-80933840.html
Basale, cancro, carcinoma, dermatologia, maligno, melanoma cutaneo, sun, tumore, illustrazione, artwork, cancerosi, insalubri, anormale, mole, lesione, medicina, medico, Foto Stockhttps://www.alamy.it/image-license-details/?v=1https://www.alamy.it/foto-immagine-basale-cancro-carcinoma-dermatologia-maligno-melanoma-cutaneo-sun-tumore-illustrazione-artwork-cancerosi-insalubri-anormale-mole-lesione-medicina-medico-80933840.htmlRFEKJRX8–Basale, cancro, carcinoma, dermatologia, maligno, melanoma cutaneo, sun, tumore, illustrazione, artwork, cancerosi, insalubri, anormale, mole, lesione, medicina, medico,
 Lo strato di pelle hanno 3 tipo di cancro in uno. Illustrazione Vettorialehttps://www.alamy.it/image-license-details/?v=1https://www.alamy.it/foto-immagine-lo-strato-di-pelle-hanno-3-tipo-di-cancro-in-uno-160366975.html
Lo strato di pelle hanno 3 tipo di cancro in uno. Illustrazione Vettorialehttps://www.alamy.it/image-license-details/?v=1https://www.alamy.it/foto-immagine-lo-strato-di-pelle-hanno-3-tipo-di-cancro-in-uno-160366975.htmlRFK8W9KY–Lo strato di pelle hanno 3 tipo di cancro in uno.
 H&E macchia, la microscopia ottica, il melanoma maligno della pelle Foto Stockhttps://www.alamy.it/image-license-details/?v=1https://www.alamy.it/foto-immagine-h-e-macchia-la-microscopia-ottica-il-melanoma-maligno-della-pelle-72482819.html
H&E macchia, la microscopia ottica, il melanoma maligno della pelle Foto Stockhttps://www.alamy.it/image-license-details/?v=1https://www.alamy.it/foto-immagine-h-e-macchia-la-microscopia-ottica-il-melanoma-maligno-della-pelle-72482819.htmlRFE5WTG3–H&E macchia, la microscopia ottica, il melanoma maligno della pelle
 Una vista macro dettagliata di una talpa con potenziali indicazioni di melanoma maligno. Concetto: Cancro della pelle Foto Stockhttps://www.alamy.it/image-license-details/?v=1https://www.alamy.it/una-vista-macro-dettagliata-di-una-talpa-con-potenziali-indicazioni-di-melanoma-maligno-concetto-cancro-della-pelle-image611046264.html
Una vista macro dettagliata di una talpa con potenziali indicazioni di melanoma maligno. Concetto: Cancro della pelle Foto Stockhttps://www.alamy.it/image-license-details/?v=1https://www.alamy.it/una-vista-macro-dettagliata-di-una-talpa-con-potenziali-indicazioni-di-melanoma-maligno-concetto-cancro-della-pelle-image611046264.htmlRF2XE3FMT–Una vista macro dettagliata di una talpa con potenziali indicazioni di melanoma maligno. Concetto: Cancro della pelle
 Melanoma maligno che colpiscono e distruggono la vita umana - simboleggiato da una figura in pillory per mostrare l'effetto maligno del melanoma e quanto cattivo, limitando un Foto Stockhttps://www.alamy.it/image-license-details/?v=1https://www.alamy.it/melanoma-maligno-che-colpiscono-e-distruggono-la-vita-umana-simboleggiato-da-una-figura-in-pillory-per-mostrare-l-effetto-maligno-del-melanoma-e-quanto-cattivo-limitando-un-image433223518.html
Melanoma maligno che colpiscono e distruggono la vita umana - simboleggiato da una figura in pillory per mostrare l'effetto maligno del melanoma e quanto cattivo, limitando un Foto Stockhttps://www.alamy.it/image-license-details/?v=1https://www.alamy.it/melanoma-maligno-che-colpiscono-e-distruggono-la-vita-umana-simboleggiato-da-una-figura-in-pillory-per-mostrare-l-effetto-maligno-del-melanoma-e-quanto-cattivo-limitando-un-image433223518.htmlRF2G4R10E–Melanoma maligno che colpiscono e distruggono la vita umana - simboleggiato da una figura in pillory per mostrare l'effetto maligno del melanoma e quanto cattivo, limitando un
 metastasi del cancro della pelle melanoma maligno. I luoghi più comuni per la diffusione del melanoma. Diagramma vettoriale Illustrazione Vettorialehttps://www.alamy.it/image-license-details/?v=1https://www.alamy.it/metastasi-del-cancro-della-pelle-melanoma-maligno-i-luoghi-piu-comuni-per-la-diffusione-del-melanoma-diagramma-vettoriale-image478676651.html
metastasi del cancro della pelle melanoma maligno. I luoghi più comuni per la diffusione del melanoma. Diagramma vettoriale Illustrazione Vettorialehttps://www.alamy.it/image-license-details/?v=1https://www.alamy.it/metastasi-del-cancro-della-pelle-melanoma-maligno-i-luoghi-piu-comuni-per-la-diffusione-del-melanoma-diagramma-vettoriale-image478676651.htmlRF2JPNGXK–metastasi del cancro della pelle melanoma maligno. I luoghi più comuni per la diffusione del melanoma. Diagramma vettoriale
 Iniezione in preparazione per un cancro alla pelle la biopsia Foto Stockhttps://www.alamy.it/image-license-details/?v=1https://www.alamy.it/foto-immagine-iniezione-in-preparazione-per-un-cancro-alla-pelle-la-biopsia-32842931.html
Iniezione in preparazione per un cancro alla pelle la biopsia Foto Stockhttps://www.alamy.it/image-license-details/?v=1https://www.alamy.it/foto-immagine-iniezione-in-preparazione-per-un-cancro-alla-pelle-la-biopsia-32842931.htmlRMBWC3DR–Iniezione in preparazione per un cancro alla pelle la biopsia
 Il melanoma maligno sulla testa di un vecchio uomo caucasico Foto Stockhttps://www.alamy.it/image-license-details/?v=1https://www.alamy.it/il-melanoma-maligno-sulla-testa-di-un-vecchio-uomo-caucasico-image229876272.html
Il melanoma maligno sulla testa di un vecchio uomo caucasico Foto Stockhttps://www.alamy.it/image-license-details/?v=1https://www.alamy.it/il-melanoma-maligno-sulla-testa-di-un-vecchio-uomo-caucasico-image229876272.htmlRFR9YNET–Il melanoma maligno sulla testa di un vecchio uomo caucasico
 Il melanoma. Pezzi di carta strappati con le parole il melanoma. In bianco e nero. Close up. Foto Stockhttps://www.alamy.it/image-license-details/?v=1https://www.alamy.it/il-melanoma-pezzi-di-carta-strappati-con-le-parole-il-melanoma-in-bianco-e-nero-close-up-image332783760.html
Il melanoma. Pezzi di carta strappati con le parole il melanoma. In bianco e nero. Close up. Foto Stockhttps://www.alamy.it/image-license-details/?v=1https://www.alamy.it/il-melanoma-pezzi-di-carta-strappati-con-le-parole-il-melanoma-in-bianco-e-nero-close-up-image332783760.htmlRF2A9BH28–Il melanoma. Pezzi di carta strappati con le parole il melanoma. In bianco e nero. Close up.
 È la fase del cancro della pelle del melanoma. L'ulcerazione è una rottura nella pelle sopra il melanoma. I melanomi ulcerati tendono ad avere una prognosi peggiore. Foto Stockhttps://www.alamy.it/image-license-details/?v=1https://www.alamy.it/e-la-fase-del-cancro-della-pelle-del-melanoma-l-ulcerazione-e-una-rottura-nella-pelle-sopra-il-melanoma-i-melanomi-ulcerati-tendono-ad-avere-una-prognosi-peggiore-image227948483.html
È la fase del cancro della pelle del melanoma. L'ulcerazione è una rottura nella pelle sopra il melanoma. I melanomi ulcerati tendono ad avere una prognosi peggiore. Foto Stockhttps://www.alamy.it/image-license-details/?v=1https://www.alamy.it/e-la-fase-del-cancro-della-pelle-del-melanoma-l-ulcerazione-e-una-rottura-nella-pelle-sopra-il-melanoma-i-melanomi-ulcerati-tendono-ad-avere-una-prognosi-peggiore-image227948483.htmlRFR6RXH7–È la fase del cancro della pelle del melanoma. L'ulcerazione è una rottura nella pelle sopra il melanoma. I melanomi ulcerati tendono ad avere una prognosi peggiore.
 Nodulari melanoma maligno. Una forma di cancro alla pelle. Foto Stockhttps://www.alamy.it/image-license-details/?v=1https://www.alamy.it/foto-immagine-nodulari-melanoma-maligno-una-forma-di-cancro-alla-pelle-12116076.html
Nodulari melanoma maligno. Una forma di cancro alla pelle. Foto Stockhttps://www.alamy.it/image-license-details/?v=1https://www.alamy.it/foto-immagine-nodulari-melanoma-maligno-una-forma-di-cancro-alla-pelle-12116076.htmlRMA8JEBW–Nodulari melanoma maligno. Una forma di cancro alla pelle.
 Il melanoma maligno è una grave forma di cancro alla pelle Foto Stockhttps://www.alamy.it/image-license-details/?v=1https://www.alamy.it/il-melanoma-maligno-e-una-grave-forma-di-cancro-alla-pelle-image6312205.html
Il melanoma maligno è una grave forma di cancro alla pelle Foto Stockhttps://www.alamy.it/image-license-details/?v=1https://www.alamy.it/il-melanoma-maligno-e-una-grave-forma-di-cancro-alla-pelle-image6312205.htmlRMA4GPTE–Il melanoma maligno è una grave forma di cancro alla pelle
 Il melanoma maligno, potenzialmente letale di cancro della pelle Foto Stockhttps://www.alamy.it/image-license-details/?v=1https://www.alamy.it/foto-immagine-il-melanoma-maligno-potenzialmente-letale-di-cancro-della-pelle-21536019.html
Il melanoma maligno, potenzialmente letale di cancro della pelle Foto Stockhttps://www.alamy.it/image-license-details/?v=1https://www.alamy.it/foto-immagine-il-melanoma-maligno-potenzialmente-letale-di-cancro-della-pelle-21536019.htmlRMB711BF–Il melanoma maligno, potenzialmente letale di cancro della pelle
 Giovane donna a prendere il sole e ottenere una tintarella sulla spiaggia, Algarve Portogallo Europa Foto Stockhttps://www.alamy.it/image-license-details/?v=1https://www.alamy.it/foto-immagine-giovane-donna-a-prendere-il-sole-e-ottenere-una-tintarella-sulla-spiaggia-algarve-portogallo-europa-71976409.html
Giovane donna a prendere il sole e ottenere una tintarella sulla spiaggia, Algarve Portogallo Europa Foto Stockhttps://www.alamy.it/image-license-details/?v=1https://www.alamy.it/foto-immagine-giovane-donna-a-prendere-il-sole-e-ottenere-una-tintarella-sulla-spiaggia-algarve-portogallo-europa-71976409.htmlRME52PJ1–Giovane donna a prendere il sole e ottenere una tintarella sulla spiaggia, Algarve Portogallo Europa
 Confronto tra mole healty e mole pericolose. Rischio di cancro della pelle. Illustrazione Foto Stockhttps://www.alamy.it/image-license-details/?v=1https://www.alamy.it/confronto-tra-mole-healty-e-mole-pericolose-rischio-di-cancro-della-pelle-illustrazione-image463699716.html
Confronto tra mole healty e mole pericolose. Rischio di cancro della pelle. Illustrazione Foto Stockhttps://www.alamy.it/image-license-details/?v=1https://www.alamy.it/confronto-tra-mole-healty-e-mole-pericolose-rischio-di-cancro-della-pelle-illustrazione-image463699716.htmlRF2HXB9M4–Confronto tra mole healty e mole pericolose. Rischio di cancro della pelle. Illustrazione
 Orecchio cancro malattia medica concetto come carta sgualcita conformato come il senso dell'udito umano parte del corpo con la presenza di aree bruciate come un melanoma e carcinoma. Foto Stockhttps://www.alamy.it/image-license-details/?v=1https://www.alamy.it/foto-immagine-orecchio-cancro-malattia-medica-concetto-come-carta-sgualcita-conformato-come-il-senso-dell-udito-umano-parte-del-corpo-con-la-presenza-di-aree-bruciate-come-un-melanoma-e-carcinoma-173519837.html
Orecchio cancro malattia medica concetto come carta sgualcita conformato come il senso dell'udito umano parte del corpo con la presenza di aree bruciate come un melanoma e carcinoma. Foto Stockhttps://www.alamy.it/image-license-details/?v=1https://www.alamy.it/foto-immagine-orecchio-cancro-malattia-medica-concetto-come-carta-sgualcita-conformato-come-il-senso-dell-udito-umano-parte-del-corpo-con-la-presenza-di-aree-bruciate-come-un-melanoma-e-carcinoma-173519837.htmlRFM28E91–Orecchio cancro malattia medica concetto come carta sgualcita conformato come il senso dell'udito umano parte del corpo con la presenza di aree bruciate come un melanoma e carcinoma.
 Esempio di come misurare la dimensione della pelle sospette freckle o mole. Sulla testa, nastro di misurazione utilizzato accanto a freckle mostra la sua dimensione. Foto Stockhttps://www.alamy.it/image-license-details/?v=1https://www.alamy.it/foto-immagine-esempio-di-come-misurare-la-dimensione-della-pelle-sospette-freckle-o-mole-sulla-testa-nastro-di-misurazione-utilizzato-accanto-a-freckle-mostra-la-sua-dimensione-56433292.html
Esempio di come misurare la dimensione della pelle sospette freckle o mole. Sulla testa, nastro di misurazione utilizzato accanto a freckle mostra la sua dimensione. Foto Stockhttps://www.alamy.it/image-license-details/?v=1https://www.alamy.it/foto-immagine-esempio-di-come-misurare-la-dimensione-della-pelle-sospette-freckle-o-mole-sulla-testa-nastro-di-misurazione-utilizzato-accanto-a-freckle-mostra-la-sua-dimensione-56433292.htmlRMD7PN6M–Esempio di come misurare la dimensione della pelle sospette freckle o mole. Sulla testa, nastro di misurazione utilizzato accanto a freckle mostra la sua dimensione.
 Il melanoma maligno Foto Stockhttps://www.alamy.it/image-license-details/?v=1https://www.alamy.it/foto-immagine-il-melanoma-maligno-49289316.html
Il melanoma maligno Foto Stockhttps://www.alamy.it/image-license-details/?v=1https://www.alamy.it/foto-immagine-il-melanoma-maligno-49289316.htmlRMCT590M–Il melanoma maligno
 Vista al microscopio del melanoma maligno Foto Stockhttps://www.alamy.it/image-license-details/?v=1https://www.alamy.it/vista-al-microscopio-del-melanoma-maligno-image368614151.html
Vista al microscopio del melanoma maligno Foto Stockhttps://www.alamy.it/image-license-details/?v=1https://www.alamy.it/vista-al-microscopio-del-melanoma-maligno-image368614151.htmlRF2CBKR33–Vista al microscopio del melanoma maligno
 Una vista macro dettagliata di una talpa con potenziali indicazioni di melanoma maligno. Concetto: Cancro della pelle Foto Stockhttps://www.alamy.it/image-license-details/?v=1https://www.alamy.it/una-vista-macro-dettagliata-di-una-talpa-con-potenziali-indicazioni-di-melanoma-maligno-concetto-cancro-della-pelle-image632785281.html
Una vista macro dettagliata di una talpa con potenziali indicazioni di melanoma maligno. Concetto: Cancro della pelle Foto Stockhttps://www.alamy.it/image-license-details/?v=1https://www.alamy.it/una-vista-macro-dettagliata-di-una-talpa-con-potenziali-indicazioni-di-melanoma-maligno-concetto-cancro-della-pelle-image632785281.htmlRF2YNDT29–Una vista macro dettagliata di una talpa con potenziali indicazioni di melanoma maligno. Concetto: Cancro della pelle
 Il melanoma, illustrazione Foto Stockhttps://www.alamy.it/image-license-details/?v=1https://www.alamy.it/il-melanoma-illustrazione-image574554893.html
Il melanoma, illustrazione Foto Stockhttps://www.alamy.it/image-license-details/?v=1https://www.alamy.it/il-melanoma-illustrazione-image574554893.htmlRF2TAN6HH–Il melanoma, illustrazione
 Il melanoma maligno in hi-ingrandimento di potenza Foto Stockhttps://www.alamy.it/image-license-details/?v=1https://www.alamy.it/foto-immagine-il-melanoma-maligno-in-hi-ingrandimento-di-potenza-146225798.html
Il melanoma maligno in hi-ingrandimento di potenza Foto Stockhttps://www.alamy.it/image-license-details/?v=1https://www.alamy.it/foto-immagine-il-melanoma-maligno-in-hi-ingrandimento-di-potenza-146225798.htmlRFJDW4DX–Il melanoma maligno in hi-ingrandimento di potenza
 Illustrazione vettoriale del melanoma uveale Illustrazione Vettorialehttps://www.alamy.it/image-license-details/?v=1https://www.alamy.it/illustrazione-vettoriale-del-melanoma-uveale-image682606672.html
Illustrazione vettoriale del melanoma uveale Illustrazione Vettorialehttps://www.alamy.it/image-license-details/?v=1https://www.alamy.it/illustrazione-vettoriale-del-melanoma-uveale-image682606672.htmlRF3BJFBNM–Illustrazione vettoriale del melanoma uveale
 Melanoma maligno e dolorosa condizione umana, raffigurata come una figura umana di legno che spinge il peso pesante per mostrare quanto può essere difficile affrontare Maligna Foto Stockhttps://www.alamy.it/image-license-details/?v=1https://www.alamy.it/melanoma-maligno-e-dolorosa-condizione-umana-raffigurata-come-una-figura-umana-di-legno-che-spinge-il-peso-pesante-per-mostrare-quanto-puo-essere-difficile-affrontare-maligna-image433172451.html
Melanoma maligno e dolorosa condizione umana, raffigurata come una figura umana di legno che spinge il peso pesante per mostrare quanto può essere difficile affrontare Maligna Foto Stockhttps://www.alamy.it/image-license-details/?v=1https://www.alamy.it/melanoma-maligno-e-dolorosa-condizione-umana-raffigurata-come-una-figura-umana-di-legno-che-spinge-il-peso-pesante-per-mostrare-quanto-puo-essere-difficile-affrontare-maligna-image433172451.htmlRF2G4MKTK–Melanoma maligno e dolorosa condizione umana, raffigurata come una figura umana di legno che spinge il peso pesante per mostrare quanto può essere difficile affrontare Maligna
 fasi di melanoma. Classificazione TNM dei tumori maligni. Metastasi del cancro della pelle. Melanoma maligno. Diagramma vettoriale Illustrazione Vettorialehttps://www.alamy.it/image-license-details/?v=1https://www.alamy.it/fasi-di-melanoma-classificazione-tnm-dei-tumori-maligni-metastasi-del-cancro-della-pelle-melanoma-maligno-diagramma-vettoriale-image478699039.html
fasi di melanoma. Classificazione TNM dei tumori maligni. Metastasi del cancro della pelle. Melanoma maligno. Diagramma vettoriale Illustrazione Vettorialehttps://www.alamy.it/image-license-details/?v=1https://www.alamy.it/fasi-di-melanoma-classificazione-tnm-dei-tumori-maligni-metastasi-del-cancro-della-pelle-melanoma-maligno-diagramma-vettoriale-image478699039.htmlRF2JPPHE7–fasi di melanoma. Classificazione TNM dei tumori maligni. Metastasi del cancro della pelle. Melanoma maligno. Diagramma vettoriale
 - Diagnosi del cancro della pelle. Concetto medico. 3D Render. Foto Stockhttps://www.alamy.it/image-license-details/?v=1https://www.alamy.it/foto-immagine-diagnosi-del-cancro-della-pelle-concetto-medico-3d-render-86226428.html
- Diagnosi del cancro della pelle. Concetto medico. 3D Render. Foto Stockhttps://www.alamy.it/image-license-details/?v=1https://www.alamy.it/foto-immagine-diagnosi-del-cancro-della-pelle-concetto-medico-3d-render-86226428.htmlRFF07XK8–- Diagnosi del cancro della pelle. Concetto medico. 3D Render.
 Il melanoma maligno sulla testa di un vecchio uomo caucasico Foto Stockhttps://www.alamy.it/image-license-details/?v=1https://www.alamy.it/il-melanoma-maligno-sulla-testa-di-un-vecchio-uomo-caucasico-image229876313.html
Il melanoma maligno sulla testa di un vecchio uomo caucasico Foto Stockhttps://www.alamy.it/image-license-details/?v=1https://www.alamy.it/il-melanoma-maligno-sulla-testa-di-un-vecchio-uomo-caucasico-image229876313.htmlRFR9YNG9–Il melanoma maligno sulla testa di un vecchio uomo caucasico
 Struttura in 3D di un melanoma cellula derivata da ion abrasione la microscopia a scansione elettronica. Foto Stockhttps://www.alamy.it/image-license-details/?v=1https://www.alamy.it/foto-immagine-struttura-in-3d-di-un-melanoma-cellula-derivata-da-ion-abrasione-la-microscopia-a-scansione-elettronica-121690966.html
Struttura in 3D di un melanoma cellula derivata da ion abrasione la microscopia a scansione elettronica. Foto Stockhttps://www.alamy.it/image-license-details/?v=1https://www.alamy.it/foto-immagine-struttura-in-3d-di-un-melanoma-cellula-derivata-da-ion-abrasione-la-microscopia-a-scansione-elettronica-121690966.htmlRMH1YE1X–Struttura in 3D di un melanoma cellula derivata da ion abrasione la microscopia a scansione elettronica.
 Pelle con carcinoma Foto Stockhttps://www.alamy.it/image-license-details/?v=1https://www.alamy.it/foto-immagine-pelle-con-carcinoma-174566048.html
Pelle con carcinoma Foto Stockhttps://www.alamy.it/image-license-details/?v=1https://www.alamy.it/foto-immagine-pelle-con-carcinoma-174566048.htmlRFM404NM–Pelle con carcinoma
 Nodulari melanoma maligno Cancro Foto Stockhttps://www.alamy.it/image-license-details/?v=1https://www.alamy.it/foto-immagine-nodulari-melanoma-maligno-cancro-12116059.html
Nodulari melanoma maligno Cancro Foto Stockhttps://www.alamy.it/image-license-details/?v=1https://www.alamy.it/foto-immagine-nodulari-melanoma-maligno-cancro-12116059.htmlRMA8JEAM–Nodulari melanoma maligno Cancro
 Il melanoma maligno in gamba inferiore Foto Stockhttps://www.alamy.it/image-license-details/?v=1https://www.alamy.it/foto-immagine-il-melanoma-maligno-in-gamba-inferiore-52502930.html
Il melanoma maligno in gamba inferiore Foto Stockhttps://www.alamy.it/image-license-details/?v=1https://www.alamy.it/foto-immagine-il-melanoma-maligno-in-gamba-inferiore-52502930.htmlRMD1BM0J–Il melanoma maligno in gamba inferiore
 Studio di abbronzatura interna chiamato Tan Express che è andato fuori del commercio Autunno 2021 nel Regno Unito. Hanno fornito una catena di saloni completamente automatizzati Foto Stockhttps://www.alamy.it/image-license-details/?v=1https://www.alamy.it/studio-di-abbronzatura-interna-chiamato-tan-express-che-e-andato-fuori-del-commercio-autunno-2021-nel-regno-unito-hanno-fornito-una-catena-di-saloni-completamente-automatizzati-image458542402.html
Studio di abbronzatura interna chiamato Tan Express che è andato fuori del commercio Autunno 2021 nel Regno Unito. Hanno fornito una catena di saloni completamente automatizzati Foto Stockhttps://www.alamy.it/image-license-details/?v=1https://www.alamy.it/studio-di-abbronzatura-interna-chiamato-tan-express-che-e-andato-fuori-del-commercio-autunno-2021-nel-regno-unito-hanno-fornito-una-catena-di-saloni-completamente-automatizzati-image458542402.htmlRM2HJ0BEA–Studio di abbronzatura interna chiamato Tan Express che è andato fuori del commercio Autunno 2021 nel Regno Unito. Hanno fornito una catena di saloni completamente automatizzati
 Leucemia diagnosi scritto nel modulo di diagnostica e pillole Foto Stockhttps://www.alamy.it/image-license-details/?v=1https://www.alamy.it/foto-immagine-leucemia-diagnosi-scritto-nel-modulo-di-diagnostica-e-pillole-139994764.html
Leucemia diagnosi scritto nel modulo di diagnostica e pillole Foto Stockhttps://www.alamy.it/image-license-details/?v=1https://www.alamy.it/foto-immagine-leucemia-diagnosi-scritto-nel-modulo-di-diagnostica-e-pillole-139994764.htmlRFJ3N8N0–Leucemia diagnosi scritto nel modulo di diagnostica e pillole
 Eraser eliminando la parola il melanoma Foto Stockhttps://www.alamy.it/image-license-details/?v=1https://www.alamy.it/eraser-eliminando-la-parola-il-melanoma-image449721280.html
Eraser eliminando la parola il melanoma Foto Stockhttps://www.alamy.it/image-license-details/?v=1https://www.alamy.it/eraser-eliminando-la-parola-il-melanoma-image449721280.htmlRM2H3JG28–Eraser eliminando la parola il melanoma
 Il cancro della pelle melanoma concetto di malattia come un simbolo di medici dell'epidermide umana anatomia essendo attaccato dal cancro maligno dark mole sagomate come testo sul corpo. Foto Stockhttps://www.alamy.it/image-license-details/?v=1https://www.alamy.it/foto-immagine-il-cancro-della-pelle-melanoma-concetto-di-malattia-come-un-simbolo-di-medici-dell-epidermide-umana-anatomia-essendo-attaccato-dal-cancro-maligno-dark-mole-sagomate-come-testo-sul-corpo-96725859.html
Il cancro della pelle melanoma concetto di malattia come un simbolo di medici dell'epidermide umana anatomia essendo attaccato dal cancro maligno dark mole sagomate come testo sul corpo. Foto Stockhttps://www.alamy.it/image-license-details/?v=1https://www.alamy.it/foto-immagine-il-cancro-della-pelle-melanoma-concetto-di-malattia-come-un-simbolo-di-medici-dell-epidermide-umana-anatomia-essendo-attaccato-dal-cancro-maligno-dark-mole-sagomate-come-testo-sul-corpo-96725859.htmlRFFHA6PY–Il cancro della pelle melanoma concetto di malattia come un simbolo di medici dell'epidermide umana anatomia essendo attaccato dal cancro maligno dark mole sagomate come testo sul corpo.
 Melanoma cellule tumorali animazione medica Foto Stockhttps://www.alamy.it/image-license-details/?v=1https://www.alamy.it/melanoma-cellule-tumorali-animazione-medica-image606512677.html
Melanoma cellule tumorali animazione medica Foto Stockhttps://www.alamy.it/image-license-details/?v=1https://www.alamy.it/melanoma-cellule-tumorali-animazione-medica-image606512677.htmlRF2X6N131–Melanoma cellule tumorali animazione medica
 Il melanoma maligno Foto Stockhttps://www.alamy.it/image-license-details/?v=1https://www.alamy.it/il-melanoma-maligno-image452594403.html
Il melanoma maligno Foto Stockhttps://www.alamy.it/image-license-details/?v=1https://www.alamy.it/il-melanoma-maligno-image452594403.htmlRM2H89CNR–Il melanoma maligno
Vista al microscopio del melanoma maligno Foto Stockhttps://www.alamy.it/image-license-details/?v=1https://www.alamy.it/vista-al-microscopio-del-melanoma-maligno-image368614165.html
Vista al microscopio del melanoma maligno Foto Stockhttps://www.alamy.it/image-license-details/?v=1https://www.alamy.it/vista-al-microscopio-del-melanoma-maligno-image368614165.htmlRF2CBKR3H–Vista al microscopio del melanoma maligno
 Su sfondo blu, uno stetoscopio, una siringa e pillole e un blocco di legno con la parola MELANOMA. Concetto medico Foto Stockhttps://www.alamy.it/image-license-details/?v=1https://www.alamy.it/su-sfondo-blu-uno-stetoscopio-una-siringa-e-pillole-e-un-blocco-di-legno-con-la-parola-melanoma-concetto-medico-image455675998.html
Su sfondo blu, uno stetoscopio, una siringa e pillole e un blocco di legno con la parola MELANOMA. Concetto medico Foto Stockhttps://www.alamy.it/image-license-details/?v=1https://www.alamy.it/su-sfondo-blu-uno-stetoscopio-una-siringa-e-pillole-e-un-blocco-di-legno-con-la-parola-melanoma-concetto-medico-image455675998.htmlRF2HD9RAP–Su sfondo blu, uno stetoscopio, una siringa e pillole e un blocco di legno con la parola MELANOMA. Concetto medico
 Stadi del melanoma, illustrazione Foto Stockhttps://www.alamy.it/image-license-details/?v=1https://www.alamy.it/stadi-del-melanoma-illustrazione-image574554853.html
Stadi del melanoma, illustrazione Foto Stockhttps://www.alamy.it/image-license-details/?v=1https://www.alamy.it/stadi-del-melanoma-illustrazione-image574554853.htmlRF2TAN6G5–Stadi del melanoma, illustrazione
 Tumori cutanei, moli e macchie, sezione 3d dello strato cutaneo. Tre tipi di cancro della pelle, carcinoma a cellule squamose, carcinoma a cellule basali, melanoma Foto Stockhttps://www.alamy.it/image-license-details/?v=1https://www.alamy.it/tumori-cutanei-moli-e-macchie-sezione-3d-dello-strato-cutaneo-tre-tipi-di-cancro-della-pelle-carcinoma-a-cellule-squamose-carcinoma-a-cellule-basali-melanoma-image346832627.html
Tumori cutanei, moli e macchie, sezione 3d dello strato cutaneo. Tre tipi di cancro della pelle, carcinoma a cellule squamose, carcinoma a cellule basali, melanoma Foto Stockhttps://www.alamy.it/image-license-details/?v=1https://www.alamy.it/tumori-cutanei-moli-e-macchie-sezione-3d-dello-strato-cutaneo-tre-tipi-di-cancro-della-pelle-carcinoma-a-cellule-squamose-carcinoma-a-cellule-basali-melanoma-image346832627.htmlRF2B47GFF–Tumori cutanei, moli e macchie, sezione 3d dello strato cutaneo. Tre tipi di cancro della pelle, carcinoma a cellule squamose, carcinoma a cellule basali, melanoma
 Illustrazione vettoriale del melanoma congiuntivale Illustrazione Vettorialehttps://www.alamy.it/image-license-details/?v=1https://www.alamy.it/illustrazione-vettoriale-del-melanoma-congiuntivale-image682606648.html
Illustrazione vettoriale del melanoma congiuntivale Illustrazione Vettorialehttps://www.alamy.it/image-license-details/?v=1https://www.alamy.it/illustrazione-vettoriale-del-melanoma-congiuntivale-image682606648.htmlRF3BJFBMT–Illustrazione vettoriale del melanoma congiuntivale
 Il melanoma maligno, il cancro della pelle, preoperatory Foto Stockhttps://www.alamy.it/image-license-details/?v=1https://www.alamy.it/foto-immagine-il-melanoma-maligno-il-cancro-della-pelle-preoperatory-81885073.html
Il melanoma maligno, il cancro della pelle, preoperatory Foto Stockhttps://www.alamy.it/image-license-details/?v=1https://www.alamy.it/foto-immagine-il-melanoma-maligno-il-cancro-della-pelle-preoperatory-81885073.htmlRFEN656W–Il melanoma maligno, il cancro della pelle, preoperatory
 ABCDE regola per la diagnosi precoce del melanoma segni e sintomi del cancro della pelle tumore maligno e talpe. Illustrazione vettoriale Illustrazione Vettorialehttps://www.alamy.it/image-license-details/?v=1https://www.alamy.it/abcde-regola-per-la-diagnosi-precoce-del-melanoma-segni-e-sintomi-del-cancro-della-pelle-tumore-maligno-e-talpe-illustrazione-vettoriale-image425405559.html
ABCDE regola per la diagnosi precoce del melanoma segni e sintomi del cancro della pelle tumore maligno e talpe. Illustrazione vettoriale Illustrazione Vettorialehttps://www.alamy.it/image-license-details/?v=1https://www.alamy.it/abcde-regola-per-la-diagnosi-precoce-del-melanoma-segni-e-sintomi-del-cancro-della-pelle-tumore-maligno-e-talpe-illustrazione-vettoriale-image425405559.htmlRF2FM2W3K–ABCDE regola per la diagnosi precoce del melanoma segni e sintomi del cancro della pelle tumore maligno e talpe. Illustrazione vettoriale
 Lavagna con il cancro della pelle del concetto. 3D'illustrazione. Foto Stockhttps://www.alamy.it/image-license-details/?v=1https://www.alamy.it/foto-immagine-lavagna-con-il-cancro-della-pelle-del-concetto-3d-illustrazione-128170677.html
Lavagna con il cancro della pelle del concetto. 3D'illustrazione. Foto Stockhttps://www.alamy.it/image-license-details/?v=1https://www.alamy.it/foto-immagine-lavagna-con-il-cancro-della-pelle-del-concetto-3d-illustrazione-128170677.htmlRFHCEK05–Lavagna con il cancro della pelle del concetto. 3D'illustrazione.
 Il melanoma parola concetto di cloud Foto Stockhttps://www.alamy.it/image-license-details/?v=1https://www.alamy.it/foto-immagine-il-melanoma-parola-concetto-di-cloud-100704524.html
Il melanoma parola concetto di cloud Foto Stockhttps://www.alamy.it/image-license-details/?v=1https://www.alamy.it/foto-immagine-il-melanoma-parola-concetto-di-cloud-100704524.htmlRFFRRDJ4–Il melanoma parola concetto di cloud
 Il melanoma sulla pelle di un paziente. Un irregolare (asimmetrica) melanoma con un irregolare ma bordo distinto, il melanoma è più di Foto Stockhttps://www.alamy.it/image-license-details/?v=1https://www.alamy.it/foto-immagine-il-melanoma-sulla-pelle-di-un-paziente-un-irregolare-asimmetrica-melanoma-con-un-irregolare-ma-bordo-distinto-il-melanoma-e-piu-di-72443793.html
Il melanoma sulla pelle di un paziente. Un irregolare (asimmetrica) melanoma con un irregolare ma bordo distinto, il melanoma è più di Foto Stockhttps://www.alamy.it/image-license-details/?v=1https://www.alamy.it/foto-immagine-il-melanoma-sulla-pelle-di-un-paziente-un-irregolare-asimmetrica-melanoma-con-un-irregolare-ma-bordo-distinto-il-melanoma-e-piu-di-72443793.htmlRME5T2P9–Il melanoma sulla pelle di un paziente. Un irregolare (asimmetrica) melanoma con un irregolare ma bordo distinto, il melanoma è più di
 Sindrome maligna neurolettica - impararla, studiarla e ispezionarla. Esaminando più da vicino la sindrome neurolettica maligna. Foto Stockhttps://www.alamy.it/image-license-details/?v=1https://www.alamy.it/sindrome-maligna-neurolettica-impararla-studiarla-e-ispezionarla-esaminando-piu-da-vicino-la-sindrome-neurolettica-maligna-image635872833.html
Sindrome maligna neurolettica - impararla, studiarla e ispezionarla. Esaminando più da vicino la sindrome neurolettica maligna. Foto Stockhttps://www.alamy.it/image-license-details/?v=1https://www.alamy.it/sindrome-maligna-neurolettica-impararla-studiarla-e-ispezionarla-esaminando-piu-da-vicino-la-sindrome-neurolettica-maligna-image635872833.htmlRF2YXEE81–Sindrome maligna neurolettica - impararla, studiarla e ispezionarla. Esaminando più da vicino la sindrome neurolettica maligna.
 Nodulari melanoma maligno cancro sulla schiena del paziente. Foto Stockhttps://www.alamy.it/image-license-details/?v=1https://www.alamy.it/foto-immagine-nodulari-melanoma-maligno-cancro-sulla-schiena-del-paziente-12116058.html
Nodulari melanoma maligno cancro sulla schiena del paziente. Foto Stockhttps://www.alamy.it/image-license-details/?v=1https://www.alamy.it/foto-immagine-nodulari-melanoma-maligno-cancro-sulla-schiena-del-paziente-12116058.htmlRMA8JEAK–Nodulari melanoma maligno cancro sulla schiena del paziente.
 Il melanoma maligno è una grave forma di cancro alla pelle Foto Stockhttps://www.alamy.it/image-license-details/?v=1https://www.alamy.it/il-melanoma-maligno-e-una-grave-forma-di-cancro-alla-pelle-image6312202.html
Il melanoma maligno è una grave forma di cancro alla pelle Foto Stockhttps://www.alamy.it/image-license-details/?v=1https://www.alamy.it/il-melanoma-maligno-e-una-grave-forma-di-cancro-alla-pelle-image6312202.htmlRMA4GPTB–Il melanoma maligno è una grave forma di cancro alla pelle
 Questa immagine ravvicinata mostra una nuova cicatrice chirurgica, la rimozione del melanoma sulla schiena di un uomo, evidenziando il processo di guarigione e il viaggio verso di essa Foto Stockhttps://www.alamy.it/image-license-details/?v=1https://www.alamy.it/questa-immagine-ravvicinata-mostra-una-nuova-cicatrice-chirurgica-la-rimozione-del-melanoma-sulla-schiena-di-un-uomo-evidenziando-il-processo-di-guarigione-e-il-viaggio-verso-di-essa-image667701670.html
Questa immagine ravvicinata mostra una nuova cicatrice chirurgica, la rimozione del melanoma sulla schiena di un uomo, evidenziando il processo di guarigione e il viaggio verso di essa Foto Stockhttps://www.alamy.it/image-license-details/?v=1https://www.alamy.it/questa-immagine-ravvicinata-mostra-una-nuova-cicatrice-chirurgica-la-rimozione-del-melanoma-sulla-schiena-di-un-uomo-evidenziando-il-processo-di-guarigione-e-il-viaggio-verso-di-essa-image667701670.htmlRF3AP8C86–Questa immagine ravvicinata mostra una nuova cicatrice chirurgica, la rimozione del melanoma sulla schiena di un uomo, evidenziando il processo di guarigione e il viaggio verso di essa
 La scrittura a mano il Melanoma con marcatore blu sul vetro trasparente stampato. Foto Stockhttps://www.alamy.it/image-license-details/?v=1https://www.alamy.it/foto-immagine-la-scrittura-a-mano-il-melanoma-con-marcatore-blu-sul-vetro-trasparente-stampato-133875642.html
La scrittura a mano il Melanoma con marcatore blu sul vetro trasparente stampato. Foto Stockhttps://www.alamy.it/image-license-details/?v=1https://www.alamy.it/foto-immagine-la-scrittura-a-mano-il-melanoma-con-marcatore-blu-sul-vetro-trasparente-stampato-133875642.htmlRFHNPFMX–La scrittura a mano il Melanoma con marcatore blu sul vetro trasparente stampato.
 Primo piano del melanoma cancro della pelle che cresce sulla pelle umana Foto Stockhttps://www.alamy.it/image-license-details/?v=1https://www.alamy.it/primo-piano-del-melanoma-cancro-della-pelle-che-cresce-sulla-pelle-umana-image633740674.html
Primo piano del melanoma cancro della pelle che cresce sulla pelle umana Foto Stockhttps://www.alamy.it/image-license-details/?v=1https://www.alamy.it/primo-piano-del-melanoma-cancro-della-pelle-che-cresce-sulla-pelle-umana-image633740674.htmlRF2YR1AKE–Primo piano del melanoma cancro della pelle che cresce sulla pelle umana
 Terapia immunoncologica o trattamento immunologico e simbolo oncologico come crescita cancerosa maligna e metastasi anatomia concetto come crescita di cellule tumorali Foto Stockhttps://www.alamy.it/image-license-details/?v=1https://www.alamy.it/terapia-immunoncologica-o-trattamento-immunologico-e-simbolo-oncologico-come-crescita-cancerosa-maligna-e-metastasi-anatomia-concetto-come-crescita-di-cellule-tumorali-image515536518.html
Terapia immunoncologica o trattamento immunologico e simbolo oncologico come crescita cancerosa maligna e metastasi anatomia concetto come crescita di cellule tumorali Foto Stockhttps://www.alamy.it/image-license-details/?v=1https://www.alamy.it/terapia-immunoncologica-o-trattamento-immunologico-e-simbolo-oncologico-come-crescita-cancerosa-maligna-e-metastasi-anatomia-concetto-come-crescita-di-cellule-tumorali-image515536518.htmlRF2MXMM2E–Terapia immunoncologica o trattamento immunologico e simbolo oncologico come crescita cancerosa maligna e metastasi anatomia concetto come crescita di cellule tumorali
 Melanoma cellule tumorali animazione medica Foto Stockhttps://www.alamy.it/image-license-details/?v=1https://www.alamy.it/melanoma-cellule-tumorali-animazione-medica-image606512699.html
Melanoma cellule tumorali animazione medica Foto Stockhttps://www.alamy.it/image-license-details/?v=1https://www.alamy.it/melanoma-cellule-tumorali-animazione-medica-image606512699.htmlRF2X6N13R–Melanoma cellule tumorali animazione medica
 Il melanoma maligno Foto Stockhttps://www.alamy.it/image-license-details/?v=1https://www.alamy.it/il-melanoma-maligno-image452594395.html
Il melanoma maligno Foto Stockhttps://www.alamy.it/image-license-details/?v=1https://www.alamy.it/il-melanoma-maligno-image452594395.htmlRM2H89CNF–Il melanoma maligno
 Vista al microscopio del melanoma maligno Foto Stockhttps://www.alamy.it/image-license-details/?v=1https://www.alamy.it/vista-al-microscopio-del-melanoma-maligno-image368614143.html
Vista al microscopio del melanoma maligno Foto Stockhttps://www.alamy.it/image-license-details/?v=1https://www.alamy.it/vista-al-microscopio-del-melanoma-maligno-image368614143.htmlRF2CBKR2R–Vista al microscopio del melanoma maligno
 Closeup talpa della pelle. Macro foto di macchia simile al melanoma, nevo marrone, piccolo segno di nascita, macchia sulla pelle umana Foto Stockhttps://www.alamy.it/image-license-details/?v=1https://www.alamy.it/closeup-talpa-della-pelle-macro-foto-di-macchia-simile-al-melanoma-nevo-marrone-piccolo-segno-di-nascita-macchia-sulla-pelle-umana-image544407728.html
Closeup talpa della pelle. Macro foto di macchia simile al melanoma, nevo marrone, piccolo segno di nascita, macchia sulla pelle umana Foto Stockhttps://www.alamy.it/image-license-details/?v=1https://www.alamy.it/closeup-talpa-della-pelle-macro-foto-di-macchia-simile-al-melanoma-nevo-marrone-piccolo-segno-di-nascita-macchia-sulla-pelle-umana-image544407728.htmlRF2PHKWH4–Closeup talpa della pelle. Macro foto di macchia simile al melanoma, nevo marrone, piccolo segno di nascita, macchia sulla pelle umana
 Stadi del melanoma, illustrazione. Foto Stockhttps://www.alamy.it/image-license-details/?v=1https://www.alamy.it/stadi-del-melanoma-illustrazione-image574554869.html
Stadi del melanoma, illustrazione. Foto Stockhttps://www.alamy.it/image-license-details/?v=1https://www.alamy.it/stadi-del-melanoma-illustrazione-image574554869.htmlRF2TAN6GN–Stadi del melanoma, illustrazione.
 Tumori cutanei, moli e macchie, sezione 3d dello strato cutaneo. Tre tipi di cancro della pelle, carcinoma a cellule squamose, carcinoma a cellule basali, melanoma Foto Stockhttps://www.alamy.it/image-license-details/?v=1https://www.alamy.it/tumori-cutanei-moli-e-macchie-sezione-3d-dello-strato-cutaneo-tre-tipi-di-cancro-della-pelle-carcinoma-a-cellule-squamose-carcinoma-a-cellule-basali-melanoma-image346176955.html
Tumori cutanei, moli e macchie, sezione 3d dello strato cutaneo. Tre tipi di cancro della pelle, carcinoma a cellule squamose, carcinoma a cellule basali, melanoma Foto Stockhttps://www.alamy.it/image-license-details/?v=1https://www.alamy.it/tumori-cutanei-moli-e-macchie-sezione-3d-dello-strato-cutaneo-tre-tipi-di-cancro-della-pelle-carcinoma-a-cellule-squamose-carcinoma-a-cellule-basali-melanoma-image346176955.htmlRF2B35M6K–Tumori cutanei, moli e macchie, sezione 3d dello strato cutaneo. Tre tipi di cancro della pelle, carcinoma a cellule squamose, carcinoma a cellule basali, melanoma
 Fasi dell'illustrazione vettoriale del melanoma Illustrazione Vettorialehttps://www.alamy.it/image-license-details/?v=1https://www.alamy.it/fasi-dell-illustrazione-vettoriale-del-melanoma-image670680871.html
Fasi dell'illustrazione vettoriale del melanoma Illustrazione Vettorialehttps://www.alamy.it/image-license-details/?v=1https://www.alamy.it/fasi-dell-illustrazione-vettoriale-del-melanoma-image670680871.htmlRF3AY4487–Fasi dell'illustrazione vettoriale del melanoma
 Il melanoma parola indicante il cancro della pelle e la malattia Foto Stockhttps://www.alamy.it/image-license-details/?v=1https://www.alamy.it/foto-immagine-il-melanoma-parola-indicante-il-cancro-della-pelle-e-la-malattia-87769390.html
Il melanoma parola indicante il cancro della pelle e la malattia Foto Stockhttps://www.alamy.it/image-license-details/?v=1https://www.alamy.it/foto-immagine-il-melanoma-parola-indicante-il-cancro-della-pelle-e-la-malattia-87769390.htmlRFF2P6N2–Il melanoma parola indicante il cancro della pelle e la malattia
 Regola ABCDE per il rilevamento precoce di melanoma Illustrazione Vettorialehttps://www.alamy.it/image-license-details/?v=1https://www.alamy.it/regola-abcde-per-il-rilevamento-precoce-di-melanoma-image389332680.html
Regola ABCDE per il rilevamento precoce di melanoma Illustrazione Vettorialehttps://www.alamy.it/image-license-details/?v=1https://www.alamy.it/regola-abcde-per-il-rilevamento-precoce-di-melanoma-image389332680.htmlRF2DHBHPG–Regola ABCDE per il rilevamento precoce di melanoma
 Il cancro della pelle la diagnosi. Concetto medico. 3D. Foto Stockhttps://www.alamy.it/image-license-details/?v=1https://www.alamy.it/foto-immagine-il-cancro-della-pelle-la-diagnosi-concetto-medico-3d-104353984.html
Il cancro della pelle la diagnosi. Concetto medico. 3D. Foto Stockhttps://www.alamy.it/image-license-details/?v=1https://www.alamy.it/foto-immagine-il-cancro-della-pelle-la-diagnosi-concetto-medico-3d-104353984.htmlRFG1NMG0–Il cancro della pelle la diagnosi. Concetto medico. 3D.
 Il melanoma parola concetto di cloud Foto Stockhttps://www.alamy.it/image-license-details/?v=1https://www.alamy.it/foto-immagine-il-melanoma-parola-concetto-di-cloud-100759036.html
Il melanoma parola concetto di cloud Foto Stockhttps://www.alamy.it/image-license-details/?v=1https://www.alamy.it/foto-immagine-il-melanoma-parola-concetto-di-cloud-100759036.htmlRFFRWY50–Il melanoma parola concetto di cloud
 Concetto - il cancro Foto Stockhttps://www.alamy.it/image-license-details/?v=1https://www.alamy.it/foto-immagine-concetto-il-cancro-26565201.html
Concetto - il cancro Foto Stockhttps://www.alamy.it/image-license-details/?v=1https://www.alamy.it/foto-immagine-concetto-il-cancro-26565201.htmlRMBF6455–Concetto - il cancro
 Primo piano di una cicatrice, dopo la rimozione (escissione) di un melanoma a diffusione superficiale (SSM) cancro della pelle. Foto Stockhttps://www.alamy.it/image-license-details/?v=1https://www.alamy.it/primo-piano-di-una-cicatrice-dopo-la-rimozione-escissione-di-un-melanoma-a-diffusione-superficiale-ssm-cancro-della-pelle-image381599820.html
Primo piano di una cicatrice, dopo la rimozione (escissione) di un melanoma a diffusione superficiale (SSM) cancro della pelle. Foto Stockhttps://www.alamy.it/image-license-details/?v=1https://www.alamy.it/primo-piano-di-una-cicatrice-dopo-la-rimozione-escissione-di-un-melanoma-a-diffusione-superficiale-ssm-cancro-della-pelle-image381599820.htmlRM2D4RAD0–Primo piano di una cicatrice, dopo la rimozione (escissione) di un melanoma a diffusione superficiale (SSM) cancro della pelle.
 La parola Melanoma sul display di una tavoletta Foto Stockhttps://www.alamy.it/image-license-details/?v=1https://www.alamy.it/la-parola-melanoma-sul-display-di-una-tavoletta-image439078994.html
La parola Melanoma sul display di una tavoletta Foto Stockhttps://www.alamy.it/image-license-details/?v=1https://www.alamy.it/la-parola-melanoma-sul-display-di-una-tavoletta-image439078994.htmlRF2GE9NMJ–La parola Melanoma sul display di una tavoletta
 Il melanoma maligno è una grave forma di cancro alla pelle Foto Stockhttps://www.alamy.it/image-license-details/?v=1https://www.alamy.it/il-melanoma-maligno-e-una-grave-forma-di-cancro-alla-pelle-image6312207.html
Il melanoma maligno è una grave forma di cancro alla pelle Foto Stockhttps://www.alamy.it/image-license-details/?v=1https://www.alamy.it/il-melanoma-maligno-e-una-grave-forma-di-cancro-alla-pelle-image6312207.htmlRMA4GPW0–Il melanoma maligno è una grave forma di cancro alla pelle
 Il cancro alla pelle del concetto. Foto Stockhttps://www.alamy.it/image-license-details/?v=1https://www.alamy.it/foto-immagine-il-cancro-alla-pelle-del-concetto-75053064.html
Il cancro alla pelle del concetto. Foto Stockhttps://www.alamy.it/image-license-details/?v=1https://www.alamy.it/foto-immagine-il-cancro-alla-pelle-del-concetto-75053064.htmlRFEA2XXG–Il cancro alla pelle del concetto.
 Molecola di farmaco di chemioterapia della procarbazina. È usato nella terapia del linfoma di Hodgkin, melanoma maligno. Modello molecolare. 3D rendering. Illustr Foto Stockhttps://www.alamy.it/image-license-details/?v=1https://www.alamy.it/molecola-di-farmaco-di-chemioterapia-della-procarbazina-e-usato-nella-terapia-del-linfoma-di-hodgkin-melanoma-maligno-modello-molecolare-3d-rendering-illustr-image475074252.html
Molecola di farmaco di chemioterapia della procarbazina. È usato nella terapia del linfoma di Hodgkin, melanoma maligno. Modello molecolare. 3D rendering. Illustr Foto Stockhttps://www.alamy.it/image-license-details/?v=1https://www.alamy.it/molecola-di-farmaco-di-chemioterapia-della-procarbazina-e-usato-nella-terapia-del-linfoma-di-hodgkin-melanoma-maligno-modello-molecolare-3d-rendering-illustr-image475074252.htmlRF2JGWE1G–Molecola di farmaco di chemioterapia della procarbazina. È usato nella terapia del linfoma di Hodgkin, melanoma maligno. Modello molecolare. 3D rendering. Illustr
 Il melanoma maligno Foto Stockhttps://www.alamy.it/image-license-details/?v=1https://www.alamy.it/foto-immagine-il-melanoma-maligno-13185036.html
Il melanoma maligno Foto Stockhttps://www.alamy.it/image-license-details/?v=1https://www.alamy.it/foto-immagine-il-melanoma-maligno-13185036.htmlRFACM3RW–Il melanoma maligno
 Fotomicrografia del melanoma, che mostra melanociti maligni, le cellule primarie responsabili del cancro cutaneo aggressivo. Foto Stockhttps://www.alamy.it/image-license-details/?v=1https://www.alamy.it/fotomicrografia-del-melanoma-che-mostra-melanociti-maligni-le-cellule-primarie-responsabili-del-cancro-cutaneo-aggressivo-image571996174.html
Fotomicrografia del melanoma, che mostra melanociti maligni, le cellule primarie responsabili del cancro cutaneo aggressivo. Foto Stockhttps://www.alamy.it/image-license-details/?v=1https://www.alamy.it/fotomicrografia-del-melanoma-che-mostra-melanociti-maligni-le-cellule-primarie-responsabili-del-cancro-cutaneo-aggressivo-image571996174.htmlRF2T6GJXP–Fotomicrografia del melanoma, che mostra melanociti maligni, le cellule primarie responsabili del cancro cutaneo aggressivo.
 Metastasi interne delle cellule del melanoma Foto Stockhttps://www.alamy.it/image-license-details/?v=1https://www.alamy.it/metastasi-interne-delle-cellule-del-melanoma-image606796172.html
Metastasi interne delle cellule del melanoma Foto Stockhttps://www.alamy.it/image-license-details/?v=1https://www.alamy.it/metastasi-interne-delle-cellule-del-melanoma-image606796172.htmlRF2X75XKT–Metastasi interne delle cellule del melanoma
 MELANOMA Foto Stockhttps://www.alamy.it/image-license-details/?v=1https://www.alamy.it/foto-immagine-melanoma-49303770.html
MELANOMA Foto Stockhttps://www.alamy.it/image-license-details/?v=1https://www.alamy.it/foto-immagine-melanoma-49303770.htmlRMCT5YCX–MELANOMA
 Vista al microscopio del melanoma maligno Foto Stockhttps://www.alamy.it/image-license-details/?v=1https://www.alamy.it/vista-al-microscopio-del-melanoma-maligno-image368614157.html
Vista al microscopio del melanoma maligno Foto Stockhttps://www.alamy.it/image-license-details/?v=1https://www.alamy.it/vista-al-microscopio-del-melanoma-maligno-image368614157.htmlRF2CBKR39–Vista al microscopio del melanoma maligno
 Closeup talpa della pelle. Macro foto di macchia simile al melanoma, nevo marrone, piccolo segno di nascita, macchia sulla pelle umana Foto Stockhttps://www.alamy.it/image-license-details/?v=1https://www.alamy.it/closeup-talpa-della-pelle-macro-foto-di-macchia-simile-al-melanoma-nevo-marrone-piccolo-segno-di-nascita-macchia-sulla-pelle-umana-image544407779.html
Closeup talpa della pelle. Macro foto di macchia simile al melanoma, nevo marrone, piccolo segno di nascita, macchia sulla pelle umana Foto Stockhttps://www.alamy.it/image-license-details/?v=1https://www.alamy.it/closeup-talpa-della-pelle-macro-foto-di-macchia-simile-al-melanoma-nevo-marrone-piccolo-segno-di-nascita-macchia-sulla-pelle-umana-image544407779.htmlRF2PHKWJY–Closeup talpa della pelle. Macro foto di macchia simile al melanoma, nevo marrone, piccolo segno di nascita, macchia sulla pelle umana
 Stadi del melanoma, illustrazione Foto Stockhttps://www.alamy.it/image-license-details/?v=1https://www.alamy.it/stadi-del-melanoma-illustrazione-image574554876.html
Stadi del melanoma, illustrazione Foto Stockhttps://www.alamy.it/image-license-details/?v=1https://www.alamy.it/stadi-del-melanoma-illustrazione-image574554876.htmlRF2TAN6H0–Stadi del melanoma, illustrazione
 Un uomo e una donna giovane che indossa cappello da sole in una calda giornata estiva in una ondata di caldo. Foto Stockhttps://www.alamy.it/image-license-details/?v=1https://www.alamy.it/un-uomo-e-una-donna-giovane-che-indossa-cappello-da-sole-in-una-calda-giornata-estiva-in-una-ondata-di-caldo-image211394959.html
Un uomo e una donna giovane che indossa cappello da sole in una calda giornata estiva in una ondata di caldo. Foto Stockhttps://www.alamy.it/image-license-details/?v=1https://www.alamy.it/un-uomo-e-una-donna-giovane-che-indossa-cappello-da-sole-in-una-calda-giornata-estiva-in-una-ondata-di-caldo-image211394959.htmlRMP7WTBY–Un uomo e una donna giovane che indossa cappello da sole in una calda giornata estiva in una ondata di caldo.
 Tipi di illustrazione vettoriale del melanoma oculare Illustrazione Vettorialehttps://www.alamy.it/image-license-details/?v=1https://www.alamy.it/tipi-di-illustrazione-vettoriale-del-melanoma-oculare-image682606689.html
Tipi di illustrazione vettoriale del melanoma oculare Illustrazione Vettorialehttps://www.alamy.it/image-license-details/?v=1https://www.alamy.it/tipi-di-illustrazione-vettoriale-del-melanoma-oculare-image682606689.htmlRF3BJFBP9–Tipi di illustrazione vettoriale del melanoma oculare
 Malattia di melanoma che indica le precarie condizioni di salute e di malessere Foto Stockhttps://www.alamy.it/image-license-details/?v=1https://www.alamy.it/foto-immagine-malattia-di-melanoma-che-indica-le-precarie-condizioni-di-salute-e-di-malessere-87789773.html
Malattia di melanoma che indica le precarie condizioni di salute e di malessere Foto Stockhttps://www.alamy.it/image-license-details/?v=1https://www.alamy.it/foto-immagine-malattia-di-melanoma-che-indica-le-precarie-condizioni-di-salute-e-di-malessere-87789773.htmlRFF2R4N1–Malattia di melanoma che indica le precarie condizioni di salute e di malessere
 Melanoma o cancro della pelle. Questo raro tipo di cancro della pelle proviene da melanociti. Strati della pelle umana. Illustrazione Vettorialehttps://www.alamy.it/image-license-details/?v=1https://www.alamy.it/melanoma-o-cancro-della-pelle-questo-raro-tipo-di-cancro-della-pelle-proviene-da-melanociti-strati-della-pelle-umana-image389332439.html
Melanoma o cancro della pelle. Questo raro tipo di cancro della pelle proviene da melanociti. Strati della pelle umana. Illustrazione Vettorialehttps://www.alamy.it/image-license-details/?v=1https://www.alamy.it/melanoma-o-cancro-della-pelle-questo-raro-tipo-di-cancro-della-pelle-proviene-da-melanociti-strati-della-pelle-umana-image389332439.htmlRF2DHBHDY–Melanoma o cancro della pelle. Questo raro tipo di cancro della pelle proviene da melanociti. Strati della pelle umana.
 Cancro della pelle - Diagnosi stampato su sfondo grigio. Foto Stockhttps://www.alamy.it/image-license-details/?v=1https://www.alamy.it/foto-immagine-cancro-della-pelle-diagnosi-stampato-su-sfondo-grigio-90787437.html
Cancro della pelle - Diagnosi stampato su sfondo grigio. Foto Stockhttps://www.alamy.it/image-license-details/?v=1https://www.alamy.it/foto-immagine-cancro-della-pelle-diagnosi-stampato-su-sfondo-grigio-90787437.htmlRFF7KM8D–Cancro della pelle - Diagnosi stampato su sfondo grigio.
 Close up foto di brown birthmark - Il nevo sulla pelle umana Foto Stockhttps://www.alamy.it/image-license-details/?v=1https://www.alamy.it/close-up-foto-di-brown-birthmark-il-nevo-sulla-pelle-umana-image156367719.html
Close up foto di brown birthmark - Il nevo sulla pelle umana Foto Stockhttps://www.alamy.it/image-license-details/?v=1https://www.alamy.it/close-up-foto-di-brown-birthmark-il-nevo-sulla-pelle-umana-image156367719.htmlRFK2B4HB–Close up foto di brown birthmark - Il nevo sulla pelle umana
 Cancer - la malattia causata da una divisione incontrollata di cellule anormali in una parte del corpo Foto Stockhttps://www.alamy.it/image-license-details/?v=1https://www.alamy.it/cancer-la-malattia-causata-da-una-divisione-incontrollata-di-cellule-anormali-in-una-parte-del-corpo-image67967836.html
Cancer - la malattia causata da una divisione incontrollata di cellule anormali in una parte del corpo Foto Stockhttps://www.alamy.it/image-license-details/?v=1https://www.alamy.it/cancer-la-malattia-causata-da-una-divisione-incontrollata-di-cellule-anormali-in-una-parte-del-corpo-image67967836.htmlRFDXG5JM–Cancer - la malattia causata da una divisione incontrollata di cellule anormali in una parte del corpo
 3d illustrazione di una sezione trasversale di una pelle malata con melanoma che entra nel flusso sanguigno e tratto linfatico Foto Stockhttps://www.alamy.it/image-license-details/?v=1https://www.alamy.it/3d-illustrazione-di-una-sezione-trasversale-di-una-pelle-malata-con-melanoma-che-entra-nel-flusso-sanguigno-e-tratto-linfatico-image362046823.html
3d illustrazione di una sezione trasversale di una pelle malata con melanoma che entra nel flusso sanguigno e tratto linfatico Foto Stockhttps://www.alamy.it/image-license-details/?v=1https://www.alamy.it/3d-illustrazione-di-una-sezione-trasversale-di-una-pelle-malata-con-melanoma-che-entra-nel-flusso-sanguigno-e-tratto-linfatico-image362046823.htmlRF2C10JBK–3d illustrazione di una sezione trasversale di una pelle malata con melanoma che entra nel flusso sanguigno e tratto linfatico
 3D immagine della formula scheletrica melfalan - struttura chimica molecolare del farmaco chemioterapico isolato su sfondo bianco Foto Stockhttps://www.alamy.it/image-license-details/?v=1https://www.alamy.it/3d-immagine-della-formula-scheletrica-melfalan-struttura-chimica-molecolare-del-farmaco-chemioterapico-isolato-su-sfondo-bianco-image491510466.html
3D immagine della formula scheletrica melfalan - struttura chimica molecolare del farmaco chemioterapico isolato su sfondo bianco Foto Stockhttps://www.alamy.it/image-license-details/?v=1https://www.alamy.it/3d-immagine-della-formula-scheletrica-melfalan-struttura-chimica-molecolare-del-farmaco-chemioterapico-isolato-su-sfondo-bianco-image491510466.htmlRF2KFJ6H6–3D immagine della formula scheletrica melfalan - struttura chimica molecolare del farmaco chemioterapico isolato su sfondo bianco
 Un melanoma maligno è un neoplasma derivato da cellule che sono in grado di formare la melanina Foto Stockhttps://www.alamy.it/image-license-details/?v=1https://www.alamy.it/un-melanoma-maligno-e-un-neoplasma-derivato-da-cellule-che-sono-in-grado-di-formare-la-melanina-image6312324.html
Un melanoma maligno è un neoplasma derivato da cellule che sono in grado di formare la melanina Foto Stockhttps://www.alamy.it/image-license-details/?v=1https://www.alamy.it/un-melanoma-maligno-e-un-neoplasma-derivato-da-cellule-che-sono-in-grado-di-formare-la-melanina-image6312324.htmlRMA4GRM5–Un melanoma maligno è un neoplasma derivato da cellule che sono in grado di formare la melanina
 Il cancro alla pelle del concetto. Foto Stockhttps://www.alamy.it/image-license-details/?v=1https://www.alamy.it/foto-immagine-il-cancro-alla-pelle-del-concetto-75053052.html
Il cancro alla pelle del concetto. Foto Stockhttps://www.alamy.it/image-license-details/?v=1https://www.alamy.it/foto-immagine-il-cancro-alla-pelle-del-concetto-75053052.htmlRFEA2XX4–Il cancro alla pelle del concetto.
 Molecola di farmaco di chemioterapia della procarbazina. È usato nella terapia del linfoma di Hodgkin, melanoma maligno. Modello molecolare. 3D rendering. Illustr Foto Stockhttps://www.alamy.it/image-license-details/?v=1https://www.alamy.it/molecola-di-farmaco-di-chemioterapia-della-procarbazina-e-usato-nella-terapia-del-linfoma-di-hodgkin-melanoma-maligno-modello-molecolare-3d-rendering-illustr-image475074194.html
Molecola di farmaco di chemioterapia della procarbazina. È usato nella terapia del linfoma di Hodgkin, melanoma maligno. Modello molecolare. 3D rendering. Illustr Foto Stockhttps://www.alamy.it/image-license-details/?v=1https://www.alamy.it/molecola-di-farmaco-di-chemioterapia-della-procarbazina-e-usato-nella-terapia-del-linfoma-di-hodgkin-melanoma-maligno-modello-molecolare-3d-rendering-illustr-image475074194.htmlRF2JGWDYE–Molecola di farmaco di chemioterapia della procarbazina. È usato nella terapia del linfoma di Hodgkin, melanoma maligno. Modello molecolare. 3D rendering. Illustr
 Tipo di cancro della pelle nel vettore 3d stile. Illustrazione Vettorialehttps://www.alamy.it/image-license-details/?v=1https://www.alamy.it/foto-immagine-tipo-di-cancro-della-pelle-nel-vettore-3d-stile-160366976.html
Tipo di cancro della pelle nel vettore 3d stile. Illustrazione Vettorialehttps://www.alamy.it/image-license-details/?v=1https://www.alamy.it/foto-immagine-tipo-di-cancro-della-pelle-nel-vettore-3d-stile-160366976.htmlRFK8W9M0–Tipo di cancro della pelle nel vettore 3d stile.
 Fotomicrografia del melanoma, che mostra melanociti maligni, le cellule primarie responsabili del cancro cutaneo aggressivo. Foto Stockhttps://www.alamy.it/image-license-details/?v=1https://www.alamy.it/fotomicrografia-del-melanoma-che-mostra-melanociti-maligni-le-cellule-primarie-responsabili-del-cancro-cutaneo-aggressivo-image571996087.html
Fotomicrografia del melanoma, che mostra melanociti maligni, le cellule primarie responsabili del cancro cutaneo aggressivo. Foto Stockhttps://www.alamy.it/image-license-details/?v=1https://www.alamy.it/fotomicrografia-del-melanoma-che-mostra-melanociti-maligni-le-cellule-primarie-responsabili-del-cancro-cutaneo-aggressivo-image571996087.htmlRF2T6GJRK–Fotomicrografia del melanoma, che mostra melanociti maligni, le cellule primarie responsabili del cancro cutaneo aggressivo.
 Cellule del melanoma metastatico all'interno del corpo Foto Stockhttps://www.alamy.it/image-license-details/?v=1https://www.alamy.it/cellule-del-melanoma-metastatico-all-interno-del-corpo-image606796169.html
Cellule del melanoma metastatico all'interno del corpo Foto Stockhttps://www.alamy.it/image-license-details/?v=1https://www.alamy.it/cellule-del-melanoma-metastatico-all-interno-del-corpo-image606796169.htmlRF2X75XKN–Cellule del melanoma metastatico all'interno del corpo
 Il melanoma maligno Foto Stockhttps://www.alamy.it/image-license-details/?v=1https://www.alamy.it/foto-immagine-il-melanoma-maligno-53862985.html
Il melanoma maligno Foto Stockhttps://www.alamy.it/image-license-details/?v=1https://www.alamy.it/foto-immagine-il-melanoma-maligno-53862985.htmlRMD3HJP1–Il melanoma maligno
 Vista al microscopio del melanoma maligno Foto Stockhttps://www.alamy.it/image-license-details/?v=1https://www.alamy.it/vista-al-microscopio-del-melanoma-maligno-image368614150.html
Vista al microscopio del melanoma maligno Foto Stockhttps://www.alamy.it/image-license-details/?v=1https://www.alamy.it/vista-al-microscopio-del-melanoma-maligno-image368614150.htmlRF2CBKR32–Vista al microscopio del melanoma maligno
 Closeup talpa della pelle. Macro foto di macchia simile al melanoma, nevo marrone, piccolo segno di nascita, macchia sulla pelle umana Foto Stockhttps://www.alamy.it/image-license-details/?v=1https://www.alamy.it/closeup-talpa-della-pelle-macro-foto-di-macchia-simile-al-melanoma-nevo-marrone-piccolo-segno-di-nascita-macchia-sulla-pelle-umana-image544407810.html
Closeup talpa della pelle. Macro foto di macchia simile al melanoma, nevo marrone, piccolo segno di nascita, macchia sulla pelle umana Foto Stockhttps://www.alamy.it/image-license-details/?v=1https://www.alamy.it/closeup-talpa-della-pelle-macro-foto-di-macchia-simile-al-melanoma-nevo-marrone-piccolo-segno-di-nascita-macchia-sulla-pelle-umana-image544407810.htmlRF2PHKWM2–Closeup talpa della pelle. Macro foto di macchia simile al melanoma, nevo marrone, piccolo segno di nascita, macchia sulla pelle umana
 Stadi del melanoma, illustrazione. Foto Stockhttps://www.alamy.it/image-license-details/?v=1https://www.alamy.it/stadi-del-melanoma-illustrazione-image574554858.html
Stadi del melanoma, illustrazione. Foto Stockhttps://www.alamy.it/image-license-details/?v=1https://www.alamy.it/stadi-del-melanoma-illustrazione-image574554858.htmlRF2TAN6GA–Stadi del melanoma, illustrazione.
 Le cellule T attaccano le cellule del cancro della prostata nell'epitelio ghiandolare prostatico - vista isometrica 3D illustrazione Foto Stockhttps://www.alamy.it/image-license-details/?v=1https://www.alamy.it/le-cellule-t-attaccano-le-cellule-del-cancro-della-prostata-nell-epitelio-ghiandolare-prostatico-vista-isometrica-3d-illustrazione-image490600812.html
Le cellule T attaccano le cellule del cancro della prostata nell'epitelio ghiandolare prostatico - vista isometrica 3D illustrazione Foto Stockhttps://www.alamy.it/image-license-details/?v=1https://www.alamy.it/le-cellule-t-attaccano-le-cellule-del-cancro-della-prostata-nell-epitelio-ghiandolare-prostatico-vista-isometrica-3d-illustrazione-image490600812.htmlRF2KE4P9G–Le cellule T attaccano le cellule del cancro della prostata nell'epitelio ghiandolare prostatico - vista isometrica 3D illustrazione